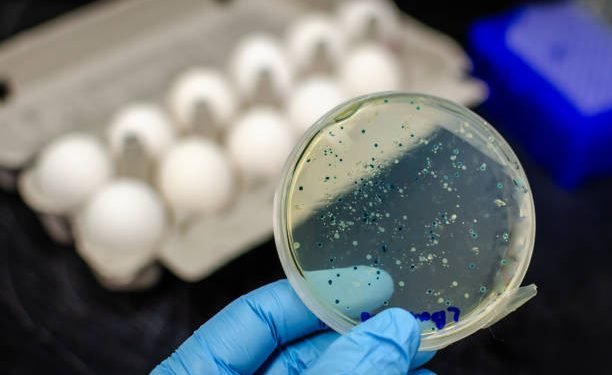
काभ्रे जिल्लाको ५० प्रतिशत खानेपानीको स्रोतमा भेटियो ‘फेइकल कोलिफर्म–इकोली’

काभ्रे । काभ्रेपलाञ्चोकको पचास प्रतिशत खानेपानी दूषित भएको परीक्षणले देखाएको छ। जिल्ला स्वास्थ्य कार्यालयले करिब दुई साताको अवधिमा जिल्लाका छ स्थानीय तहका खानेपानी आयोजनाका पानी परीक्षणबाट सबै खानेपानी दूषित भएको पुष्टि भएको जनाएको हो।
कार्यालयद्वारा सदरमुकामस्थित धुलिखेल तथा प्रमुख सहर बनेपा, पनौती, पाँचखाल, भम्लुलगायत जिल्लास्थित आधा स्थानीय तहको खानेपानी नमुनाका रूपमा परीक्षणका क्रममा पानीजन्य रोगको जोखिम पुष्टि भएको जनाइएको छ। परीक्षण गरिएका सबै खानेपानीमा दिसाजन्य कीटाणु (फेइकल कोलिफर्म–इकोली) भेटिएको कार्यालयका प्रमुख डा पुरुषोत्तम सेढाईंले बताए। उनका अनुसार परीक्षणबाट खानेपानी संस्थानद्वारा वितरण भइरहेको तथा स्थानीय खानेपानी आयोजनाद्वारा वितरित पानीमा दिसाजन्य कीटाणु भेटिएको हो।
‘जिल्लाको आधा स्थानीय तहमा गरिएको खानेपानी परीक्षणबाट सबै खानेपानी दूषित पाइएको छ’, स्वास्थ्य कार्यालय डा सेढाईंले भने। अनुगमन तथा परीक्षणका क्रममा कतिपय खानेपानीको स्रोत तथा सङ्कलन केन्द्र ट्याङ्कीको पानी दूषित देखिएको जनाइएको छ। कतिपय स्थानमा वितरीत जारको खानेपानीमा समेत दिसाजन्य कीटाणु भेटिएको उनले बताए।
काभ्रेपलाञ्चोकमा १३ स्थानीय तह छ।
खानेपानी दूषित हुने समस्या अझै केही समय रहने भएकाले सचेत रहन आग्रह गरिएको छ। ‘हामी अझै शङ्कास्पद क्षेत्रको खानेपानी परीक्षणकै क्रममा छौँ, त्यसैले पानी उमालेर, फिल्टर गरेर वा तोकिएको मात्रामा क्लोरिन झोल हालेरमात्रै पानी पिउनुपर्छ’, उनले भने।
दुई सातादेखि नै जिल्ला स्वास्थ्य कार्यालय, नमोबुद्ध नगरस्थित मेथिनकोट अस्पताल तथा नगर र गाउँपालिकाको समन्वयमा स्थानीयस्तरका खानेपानी परीक्षण, औषधि व्यवस्थापनकार्य तथा खानेपानी शुद्ध बनाउनेबारे चेतनामूलक कार्यक्रम सञ्चालन गर्ने तयारी भएको जनाइएको छ। कार्यालयले जोखिममा द्रूत प्रतिकार्य टोली तयारी अवस्थामा राखिएको समेत स्वास्थ्य प्रमुख सेढाईंले बताए। उनले भने ‘सम्भावित हैजाको महामारी रोकथामको प्रयास गरिरहेका छौं।’
कार्यालयले पातलो चौलानीको पानीजस्तो पखाला लाग्ने, खान–पिउन नसकी झन् बिरामी भएमा, दिसामा रगत देखिएमा, तारन्तार वान्ता भएमा, बालबालिका ज्यादै तिर्खाएमा, उच्च मात्रामा ज्वरो आएमा, धेरै पटक पातलो दिसा गरेमा उपचारार्थ तुरुन्तै स्वास्थ्य संस्थामा जान तथा लैजान अपिलसमेत गरेको छ। दूषित पानीका कारण हैजा सबै उमेर समूहलाई हुने भए पनि बालबालिका, गर्भवती तथा वृद्ध वृद्धा बढी जोखिममा पर्ने भएकाले सजग रहन विशेष अपिल गरिएको हो।
यस्तै खाना बनाउनुअघि र पछि, दिसा पिसाब गरेपछि र फोहर चलाएपछि राम्रोसँग साबुन पानीले हात धुन पनि आग्रह गरिएको छ। यस्तै खानेपानी सधैँ सफा भाँडोले छोप्न, खानेकुरा राम्ररी पकाएर खान, सडेगलेको, बासी र झिँगा भन्केको खानेकुरा नखानसमेत अनुरोध गरिएको छ।